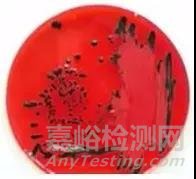
GB 4789.4-2016 沙門氏菌的檢驗過程及操作時的注意事項
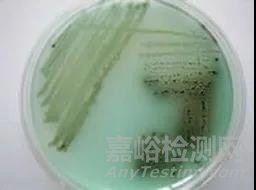
GB 4789.4-2016 沙門氏菌的檢驗過程及操作時的注意事項
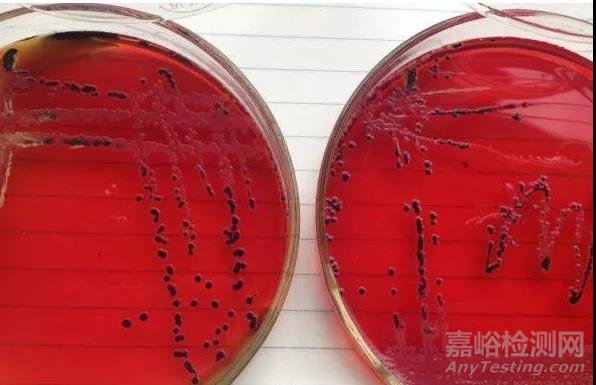
GB 4789.4-2016 沙門氏菌的檢驗過程及操作時的注意事項
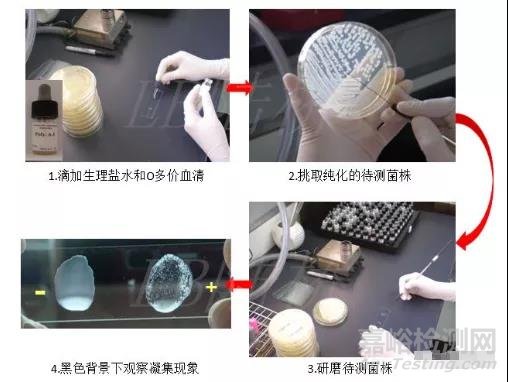
GB 4789.4-2016 沙門氏菌的檢驗過程及操作時的注意事項

您當前的位置:檢測資訊 > 法規(guī)標準
嘉峪檢測網 2021-08-09 13:47
在我們平時的微生物檢測工作中,沙門氏菌是非常常見的檢測項目之一,沙門氏菌屬于致病性細菌,要求在食品中每25g樣品中不得檢出沙門氏菌,因此對于沙門氏菌檢測過程中的培養(yǎng)基和試劑的要求比較高,在這里跟大家討論一下沙門氏菌的檢驗過程及操作時的注意事項。
01預增菌
樣品加入緩沖蛋白胨水(BPW)中進行預增菌,任何樣品均需進行預增菌。有盆友問啦,為什么要用BPW呢?那是因為啊,食品在加工過程中采用加熱、干燥等加工工藝使得細胞存在不同程度的受損,而緩沖蛋白胨水(BPW)呢,作為非選擇性的增菌培養(yǎng)基,較高pH的緩沖體系可以幫助受損的細胞恢復到穩(wěn)定、活力滿滿的生理狀態(tài),此處也可使用即用型的BPW,因為它操作方便,節(jié)省時間。
02選擇性增菌
這里要注意啦,增菌接種前一定要把預增菌后的BPW樣品溶液輕輕搖動混勻,這樣做的原因是有些沙門君是懶得動的(因為有些沙門氏菌沒鞭毛),它們會潛伏在溶液底層,所以我們要把增菌液“搖擺、搖擺”,讓不動的沙門君們在增菌液中都漂浮起來,吸出,分別接入TTB和SC培養(yǎng)基中。


此步驟防止漏檢的方式是采用兩種不同的選擇性增菌液(TTB和SC)進行增菌,是因為沙門君的家族太龐大了,血清型都有2000多種,所以得加強引誘措施,采用不同的培養(yǎng)溫度和不同抑制性的培養(yǎng)基來給不同的沙門君提供安逸的環(huán)境來繁衍后代,同時盡量阻攔革蘭氏陽性菌和其他大多數(shù)的腸道菌來搗亂,有些細菌還是會趁虛而入的。
咱們來說一下TTB和SC使用過程中的注意事項:
TTB培養(yǎng)基:待基礎培養(yǎng)基冷卻至50℃以下時,加入煌綠和碘液,因為培養(yǎng)基中含有不溶解的CaCO3(用來中和吸收有毒性的代謝物質),會有大量的白色沉淀,在分裝時應邊搖勻邊分裝,接種后培養(yǎng)條件為:42℃±1℃培養(yǎng)18h-24h;
SC培養(yǎng)基:千萬不可高壓滅菌,不可過度加熱,最好是現(xiàn)用現(xiàn)配。發(fā)現(xiàn)干粉或溶液變紅就不要使用了。培養(yǎng)基開封后建議用封口膜密封后冷藏保存,可延緩培養(yǎng)基變質,接種后培養(yǎng)條件為:36℃±1℃培養(yǎng)18h-24h;
03分離
TTB與SC增菌液在接種選擇性分離培養(yǎng)基前,均應輕輕搖動混勻,原因同選擇性增菌一樣,也是為了防止不運動的沙門氏菌漏檢;混勻后,用直徑為3mm的接種環(huán)(也就是實驗室用的10μL接種環(huán))將TTB與SC增菌液“分別”劃線接種于兩種選擇性平板,一種是BS瓊脂,為必選的選擇性分離培養(yǎng)基,另外一種選擇性分離培養(yǎng)基是從XLD瓊脂、HE瓊脂、沙門顯色培養(yǎng)基中選擇一個即可;沙門氏菌屬在不同選擇性瓊脂平板上的菌落特征參考下圖:

注意:在一種選擇性瓊脂培養(yǎng)基上不同沙門氏菌會長出不同的菌落形態(tài),在做樣品檢驗時要參考上圖中沙門氏菌的菌落特征,將典型菌落及可疑菌落純化后做生化和血清鑒定,避免漏檢,例如:在XLD瓊脂接菌培養(yǎng)18h-24h時,鼠傷寒沙門氏菌為粉紅色菌落,呈現(xiàn)大的帶光澤的黑色中心,大腸埃希氏菌為黃色菌落,豬霍亂沙門氏菌為淡黃色菌落,比大腸埃希氏菌的顏色略淺,易混淆,為防止漏檢,XLD瓊脂平板上黃色菌落也應做生化和血清鑒定,不可忽視。
咱們來說一下選擇性瓊脂培養(yǎng)基使用過程中的注意事項:
BS瓊脂:配制時不可高壓,煮沸滅菌即可,不可反復溶解,避免降低其選擇性;特別需要注意的一點是必須使用前一天配制,且在48h內使用,超過48h也會降低其選擇性,請于室溫暗處貯存,接種后培養(yǎng)條件為:36℃±1℃培養(yǎng)40h-48h;
XLD瓊脂:配制時不可高壓,煮沸滅菌即可,不可反復溶解,避免降低其選擇性,請于室溫暗處貯存;該培養(yǎng)基宜于當天配置,第二天使用,接種后培養(yǎng)條件為:36℃±1℃培養(yǎng)18h-24h;
HE瓊脂:配制時不可高壓,煮沸滅菌即可,不可反復溶解,避免降低其選擇性;接種后培養(yǎng)條件為:36℃±1℃培養(yǎng)18h-24h;
04生化實驗
沙門氏菌的生化和血清學鑒定試驗的操作較繁瑣,也有較多的操作點需要注意,否則檢測結果容易出錯。
1.三糖鐵瓊脂和賴氨酸脫羧酶試驗
根據GB 4789.4-2016的表1中沙門氏菌屬的典型菌落特征描述,從選擇性瓊脂平板上分別挑取2個以上典型或可疑菌落(用接種針自菌落中心挑取),直接接種于三糖鐵瓊脂和賴氨酸脫羧酶試驗培養(yǎng)基,同時用接種環(huán)挑取相同菌落劃線營養(yǎng)瓊脂平板進行純化,36℃±1℃培養(yǎng)16h-24h,必要時可延長培養(yǎng)至48h。
1.1三糖鐵試驗
注意 三糖鐵瓊脂接種時先在斜面劃線,再于底層穿刺,但高層穿刺時接種針不能穿到底部,接種太深,否則有些菌產生的硫化氫會布滿試管底部,影響底層培養(yǎng)基顏色變化的觀察。

建議接種后的三糖鐵瓊脂安瓿瓶用封口膜輕輕的覆蓋在瓶口,防止培養(yǎng)過程中培養(yǎng)基失水干縮后氧氣進入,底部的黃色被氧化變色,影響結果觀察;再用接種針在封口膜上扎些小孔利于培養(yǎng)過程中氧氣的供應。
1.2賴氨酸脫羧酶試驗
原理:某些細菌在酸性厭氧環(huán)境,且有賴氨酸底物存在的情況下能誘導產生賴氨酸脫羧酶,使賴氨酸脫羧產生堿性物質尸胺,導致培養(yǎng)基變紫,但不產生賴氨酸脫羧酶的細菌只能代謝葡萄糖產酸培養(yǎng)基變黃。
注意 在進行賴氨酸脫羧酶試驗時,注意要挑取同一個待檢菌落同時接種氨基酸脫羧酶對照管和賴氨酸脫羧酶試驗管各一支,接種后在對照管和試驗管液面上方均需加無菌液體石蠟(一定要是無菌的)覆蓋。
您是否疑問為什么非要加無菌的液體石蠟?
由于氨基酸脫羧的產物尸胺、腐胺等遇氧不穩(wěn)定,所以需要加無菌液體石蠟覆蓋隔絕空氣,保持胺的穩(wěn)定性,確保試驗結果的真實性。
1.3生化結果初步判斷
根據三糖鐵瓊脂和賴氨酸脫羧酶試驗結果,參考GB 4789.4-2016中表2來初步判斷是否有可疑的沙門氏菌。

根據表2的描述,如果遇到①三糖鐵瓊脂的試驗管底部變紅;②整個三糖鐵瓊脂試管為黃色,并且賴氨酸脫羧酶試驗為陰性的試驗結果時,說明該菌株為非沙門氏菌,不需再做后續(xù)的生化試驗。
2.靛基質、尿素酶和氰化鉀生長試驗
如果初步判斷符合可疑沙門氏菌屬的生化結果時,挑取純化好的可疑菌落,再繼續(xù)做靛基質、尿素酶和氰化鉀生長試驗,這三步試驗也可與三糖鐵瓊脂、賴氨酸脫羧酶試驗同時做,36℃±1℃培養(yǎng)16h-24h,必要時可延長培養(yǎng)至48h,純化后的營養(yǎng)瓊脂平板儲存于2℃-5℃或室溫至少保留24h,以便進行后續(xù)的生化試驗和必要時復查。
2.1靛基質試驗
將純化后的可疑菌株接種至蛋白胨水中,36℃±1℃培養(yǎng)18h-24h,培養(yǎng)后沿管壁緩慢的加入柯凡克試劑或歐-波試劑,若此可疑菌株可分解蛋白胨中的色氨酸生成吲哚,吲哚與靛基質試劑中的對二甲氨基苯甲醛反應生成紅色的玫瑰吲哚,為陽性;若不分解色氨酸則仍是黃色,為陰性。

2.2尿素酶試驗
某些細菌產生的尿素酶分解尿素可產生大量的堿性物質-氨,使培養(yǎng)基pH值升高,指示劑酚紅變成紅色,為陽性;
在試驗操作時,應待滅菌后的尿素瓊脂基礎冷卻至55℃時,再每95mL基礎中加入5mL 40%尿素水,防止基礎溫度過高使尿素水分解,充分混勻后分裝試管,制成斜面。

2.3氰化鉀試驗
該試驗的目的是為了鑒別細菌能否被一定濃度的氰化鉀抑制而導致細菌不生長;若試驗管生長渾濁為陽性,不生長且澄清的為陰性。
注意 在進行試驗操作時,應將同一株可疑菌同時接種氰化鉀對照管和試驗管各一支;
氰化鉀試驗操作時易失敗的主要原因:
在氰化鉀對照管和試驗管接種可疑菌株后,應使用無菌的液體石蠟覆蓋液面,若不覆蓋,氰化鉀會逐漸分解,產生氫氰酸氣體逸出,以致氰化鉀濃度降低,細菌生長,造成假陽性的結果。
氰化鉀為劇毒物質,可抑制呼吸酶,造成細胞內窒息,吸入、口服或經皮膚吸收均可引起急性中毒,在操作該試驗時應做好個人防護,避免接觸、入口或吸入。
2.4生化結果鑒定廢棄處理
試驗結果觀察結束后,在每管中加入0.5mL的40%氫氧化鉀溶液和數(shù)粒硫酸亞鐵,反應數(shù)小時后,建議121℃高壓滅菌30min,廢棄。
根據以上的試驗結果,查詢表3對沙門氏菌屬進行初步鑒定:
反應序號A1:

當試驗結果符合A1時,為沙門氏菌屬的典型反應,生化結果可初步判定為沙門氏菌;
若此表格中,有1項不符合時,再參考表4中的“判定結果”再進行血清或生化的驗證試驗;
若有2項結果不符合時,判定為非沙門氏菌。
表4判定結果解讀:

若試驗結果為第1種情況時,生化結果初步鑒定為甲型副傷寒沙門氏菌,需通過查詢WKLM抗原表,確定甲型副傷寒沙門氏菌的O抗原和H抗原的因子,再進行血清學的驗證試驗。
若試驗結果為第2種情況時,生化結果初步鑒定為沙門氏菌IV或V,若需分清是IV還是V,就需要按照表5做相應的生化試驗再進行分群,最終的鑒定還需要參考血清學鑒定的結果共同確定。

若試驗結果為第3種情況時,生化結果初步鑒定為沙門氏菌個別變體,需要再做血清學鑒定試驗。
反應序號A2:
當試驗結果符合A2時,需要再做甘露醇和山梨醇兩項試驗,若補做的甘露醇和山梨醇均為陽性結果時,繼續(xù)做血清學鑒定試驗,結合血清學的試驗結果進行判定;
反應序號A3:
當試驗結果符合A3時,需補做ONPG試驗;
若賴氨酸脫羧酶為陽性,ONPG為陰性時生化結果初步判定為沙門氏菌;
若賴氨酸脫羧酶和ONPG的結果均為陰性時,生化結果初步判定為甲型副傷寒沙門氏菌。
05血清學鑒定
血清學鑒定試驗是必做的項目,血清學分型為選做項目可根據各自實驗室的需求選擇。
實驗室應配備沙門氏菌多價菌體(O)和多價鞭毛(H)診斷血清。
1. 沙門氏菌屬的抗原結構簡介
O抗原:也稱為菌體抗原,是細胞壁的組成成分,O抗原與抗血清的反應呈顆粒狀;
H抗原:也稱為鞭毛抗原,不同細菌的H抗原具有特異性,常作為血清學鑒定的依據之一;H抗原與抗血清的反應呈絮狀或絨狀,大部分沙門氏菌H抗原都有兩相,第一相被稱為特異性相,第二相為非特異性相;
Vi抗原:是一種特殊的菌體抗原,屬于K抗原群,如傷寒沙門氏菌、丙型副傷寒沙門氏菌和都柏林沙門氏菌都含有Vi抗原。
2. 培養(yǎng)物自凝性的檢查
在一塊潔凈的玻片上滴加一滴生理鹽水,挑取瓊脂量為1.2%-1.5%的培養(yǎng)基平板上純化的菌株,混合于生理鹽水滴中,混勻,成為均一性的混濁懸液,將玻片輕輕混動30s-60s,置于黑色背景下觀察凝集情況,若出現(xiàn)可見的菌體凝集,則認為有自凝性,說明該菌株發(fā)生S-R變異,失去了O抗原成為粗糙型,不能進行血清學鑒定試驗;反之無自凝性,若無自凝性則繼續(xù)做后續(xù)的血清學試驗。

注意 在做血清學鑒定試驗中,菌株建議使用純化培養(yǎng)18-24h的新鮮菌株;
菌株純化時,建議使用營養(yǎng)瓊脂培養(yǎng)基,盡量不用平板計數(shù)瓊脂,是因為平板計數(shù)瓊脂配方中含有糖類,糖類會干擾血清學的鑒定;營養(yǎng)瓊脂培養(yǎng)基的瓊脂量在1.2%-1.5%之間。
3. O多價菌體抗原的鑒定
在潔凈的玻片的一邊滴加一滴生理鹽水作為對照,另一邊滴加一滴O多價血清;
自營養(yǎng)瓊脂平板挑取1環(huán)純化后的待測菌,在生理鹽水滴和多價菌體(O)抗血清滴上方各放1/2環(huán)待測菌,再用無菌的接種環(huán)分別將兩個區(qū)域內的菌苔研磨成乳液狀,將玻片輕輕混動1min,置于黑色背景下觀察,任何程度的凝集現(xiàn)象皆為陽性反應。
注意 研磨菌株時應先研磨生理鹽水區(qū)域,再研磨O多價血清區(qū)域;若先研磨O多價血清區(qū)域,再研磨生理鹽水區(qū)域,有可能會把O多價血清帶入到生理鹽水區(qū)域,造成誤判。
若O多價不凝集時就判定為非沙門氏菌嗎?
此時需要考慮是否因為莢膜的原因而導致的O多價不凝集,分為以下兩步進行排除:
I.將菌株接種在瓊脂量較高(2%-3%)的培養(yǎng)基上,培養(yǎng)后,再進行O多價凝集試驗,這里說的高瓊脂量的培養(yǎng)基,可以在實驗室中,按每100mL營養(yǎng)瓊脂培養(yǎng)基(脫水干粉培養(yǎng)基)中加入1g的瓊脂,再高壓滅菌,倒平板備用。
在較高瓊脂量的培養(yǎng)基上再純化的原因:因為菌株在瓊脂量較高的培養(yǎng)基上莢膜發(fā)育不良,可以暴漏出O抗原,有利于檢測是否有菌體抗原存在;
II.若是因為有Vi抗原存在而阻止O凝集反應時,可多挑取純化后的待測菌株置于1mL生理鹽水中制成濃菌液,煮沸,破壞莢膜的多糖和抗原,暴露O抗原,需要待菌液冷卻后再進行O多價血清的鑒定。
4.H多價鞭毛抗原的鑒定
操作與O多價鑒定步驟相同;
但H抗原發(fā)育不良時,H多價血清也會不凝集,此時需要將菌株接種瓊脂量更低(0.55%-0.65%)的半固體瓊脂平板中央,培養(yǎng)后,菌株蔓延生長至平板的邊緣時,取最邊緣的菌株進行H多價血清凝集試驗;
注意 若培養(yǎng)后菌株未蔓延生長,則需要再次轉種半固體瓊脂培養(yǎng)基,直至蔓延生長;
為什么H多價血清鑒定需要瓊脂量更低的半固體瓊脂平板?
因為H多價血清的鑒定需要菌株的鞭毛發(fā)育良好,而培養(yǎng)基的瓊脂量更低時,含有的水分就越多,越有利于菌株鞭毛的發(fā)育和爬行。
促進鞭毛發(fā)育的另一種方法是將菌株通過接種裝有0.3%-0.4%半固體瓊脂的小玻管1-2次,自遠端取菌培養(yǎng)后再檢查,該方法操作較復雜。
06結果與報告
綜合以上生化試驗和血清學鑒定的結果,報告25g(mL)樣品中檢出或未檢出沙門氏菌。
注意 報告結果不能只參考生化試驗或血清學鑒定的結果,而應該綜合考慮生化和血清學兩項的共同結果來判斷。

來源:陸橋官網